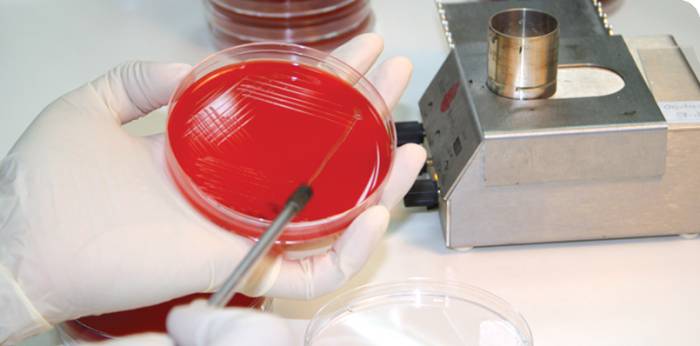
bact00

Бактериальный посев мочи — это лабораторный метод диагностики, который позволяет определить наличие микроорганизмов, а также их количество в моче. Исследование достаточно часто назначается врачами. Так, его проводят при подозрении на инфекционные заболевания органов мочевыделительной системы. Кроме того, бактериальный посев мочи в обязательном порядке делают беременным.
Подготовка к исследованию
Чтобы результаты исследования были достоверными, нужно правильно осуществить сбор мочи. Рекомендуется производить забор мочи утром, после пробуждения. Прежде всего, нужно провести туалет наружных половых органов без использования мыла, интимных гелей и прочих антисептических средств. Затем следует промокнуть промежность чистым полотенцем. Во время менструации медики рекомендуют женщинам использовать тампоны при собирании мочи для анализа.
Чтобы предотвратить искажение результатов, посуда, используемая для хранения мочи, должна быть стерильна. В советское время человеку перед исследованием нужно было идти в лечебное учреждение, где ему выдавали стерильную баночку. К счастью, сейчас все намного проще: достаточно зайти в ближайшую аптеку и приобрести контейнер для мочи.
Для бактериального исследования необходимо собрать в емкость среднюю порцию мочи. Это значит, что первая порция мочи спускается в унитаз, затем необходимо задержать мочеиспускание, поднести емкость и наполнить мочой. Заполненный контейнер можно закрыть крышкой и отставить в сторону. Заключительную порцию мочи нужно слить в унитаз.
Важно: нельзя прикасаться к внутренней поверхности контейнера пальцами. Этого можно избежать, если держать емкость непосредственно у основания.
На качество результата бак посева влияет и своевременность проведения исследования. Поэтому мочу нужно принести в лабораторию в течение двух-трех часов.
Врачи подчеркивают важность правильной подготовки к бакпосеву мочи для получения достоверных результатов. Перед сдачей анализа рекомендуется избегать употребления антибиотиков за 48 часов до процедуры, так как они могут исказить результаты. Также следует избегать чрезмерного употребления жидкости, чтобы не разбавить мочу. Специалисты советуют проводить гигиенические процедуры перед сбором образца, чтобы минимизировать риск контаминации.
Расшифровка результатов анализа требует внимания. Нормальные показатели могут варьироваться, но наличие бактерий, белка или крови в моче может указывать на инфекцию или другие патологии. Врачи напоминают, что интерпретация результатов должна проводиться квалифицированным специалистом, который учитывает клиническую картину и сопутствующие симптомы пациента. Правильная подготовка и грамотная расшифровка анализа играют ключевую роль в диагностике и лечении заболеваний мочевыводящей системы.

Показания к проведению бак посева мочи
Бак посев мочи проводят в таких случаях:
- При подозрении на наличие воспалительного процесса в мочевыделительных органах;
- Для контроля эффективности антибактериального лечения заболеваний мочевыделительной системы;
- Во время беременности.
Кроме того, проведение бак посева мочи совместно с антибиотикограммой позволит определить наиболее эффективный антибактериальный препарат для лечения инфекции.
Методика выполнения бак посева мочи
Лаборант наносит образцы мочи на специальные питательные среды, размешенных в чашках Петри. Среды помещаются в термостаты, где созданы оптимальные условия для роста микроорганизмов. Через определенные промежутки времени лаборант осматривает питательные среды. Рост микроорганизмов происходит в виде колоний. Концентрация патогенных микроорганизмов измеряется в КОЕ — колониеобразующих единиц. То есть это то число колоний, которое вырастет из одной клетки.
В состав нормальной микрофлоры мочевыделительных путей входят стафилококки (St. epidermidis), стрептококки (Str. faecalis). При инфекциях органов мочеполовой системы в моче определяются:
- Кишечная палочка (Escherichia coli);
- Сапрофитный стафилококк (Staphylococcus saprophyticus);
- Синегнойная палочка (Pseudomonas aeruginosa);
- Протеи (Proteus mirabilis);
- Клебсиелы (Klebsiella pneumonia).
Бакпосев мочи — это важный анализ, который помогает выявить наличие инфекций в мочевыводящих путях. Подготовка к его сдаче требует соблюдения определенных правил. Врачи рекомендуют избегать употребления антибиотиков за несколько дней до анализа, так как они могут исказить результаты. Также стоит отказаться от алкоголя и острого питания, чтобы не повлиять на состав мочи.
Перед сдачей анализа важно тщательно провести гигиенические процедуры, чтобы избежать загрязнения образца. Лучше всего собирать среднюю порцию мочи в стерильный контейнер. Расшифровка результатов может занять несколько дней, и в ней учитываются как количество, так и вид бактерий, а также их чувствительность к антибиотикам. Это позволяет врачу назначить правильное лечение и предотвратить осложнения.

Расшифровка результатов бакпосева мочи
Моча человека не стерильна, поэтому выделение микроорганизмов в малых концентрациях (менее 103 микробных клеток в 1 мл) является нормой. Бактериурия, равная 104 микробных клеток в 1 мл, оценивается как сомнительный результат. Более 105 микробных клеток в 1 мл свидетельствует о наличии инфекции в мочеиспускательных органах. Результаты бактериального посева мочи человек сможет получить через пять-десять дней.
Этот метод диагностики позволяет определить наличие инфекционного процесса в мочеполовой системе, но не дает информации о том, в каком именно органе локализован воспалительный процесс. Разобраться в этом помогут результаты проведенной трехстаканной пробы мочи.
Бактериурия у беременных
Как только беременная женщина становится на учет в женскую консультацию, ей тут же выписывают кучу направлений для прохождения всевозможных исследований, среди которых и бактериальный посев мочи. Затем бак посев мочи беременные повторяют на 36-й неделе беременности.
Бактериальный посев мочи позволит выявить у беременной пиелонефрит. Анатомические особенности мочеполовой системы женского организма объясняют предрасположенность к развитию пиелонефрита. Так, у многих женщин имеется инфекционный процесс в почках, о котором впрочем, они могут и не догадываться. При беременности инфекционный процесс активизируется, что представляет опасность не только для женщины, но и ребенка.
Пиелонефрит у беременных развивается вследствие таких причин:
- Снижение тонуса мочеточников, что приводит к застою мочи и размножению бактерий;
- Увеличенная матка сдавливает мочевыделительные пути, что также приводит к застою мочи.
Пиелонефрит беременных встречается приблизительно в 3-10% всех случаев. Именно из-за такой высокой распространенности заболевания всем проводят бак посев мочи беременным.
Стоит отметить, что при однократном культуральном исследовании мочи нередко возникают ложноположительные результаты. Поэтому всем беременным с положительными результатами бак посева следует повторить исследование спустя одну-две недели, уделив пристальное внимание тщательному туалету наружных половых органов перед забором мочи.
Григорова Валерия, медицинский обозреватель

Вопрос-ответ
Как сдают анализы на бакпосев?
Для анализа следует собирать среднюю порцию утренней мочи. Начать мочеиспускание в унитаз, среднюю порцию собрать в стерильный одноразовый контейнер в количестве 10-20 мл, закончить мочеиспускание в унитаз. Пробу необходимо доставить в лабораторию не позднее 2 часов с момента сбора.
Как подготовиться к сдаче анализа мочи на бакпосев?
Как подготовиться к бактериологическому исследованию мочи Промежность и область заднего прохода необходимо промыть теплой кипяченой водой, а затем высушить чистой и сухой марлевой салфеткой. При мочеиспускании нужно держать крайнюю плоть оттянутой, для предотвращения загрязнения пробы мочи микроорганизмами с кожи.
Как расшифровать результат анализа мочи на бакпосев?
До 1000 КОЕ/мл – пациентка здорова, лечение не требуется, 1000 – 100000 КОЕ/мл – ложный результат, требуется повторная сдача биоматериала, выше 100000 КОЕ/мл – прогрессирующее воспаление или инфекция, требуется срочное лечение.
Что нельзя делать перед сдачей мочи на бак посев?
Накануне исследования не рекомендуется принимать алкоголь, соленую и острую пищу, мочегонные препараты, а также БАДы и пищевые продукты, изменяющие цвет мочи (свекла, морковь). После проведения цистоскопии анализ мочи можно назначать не ранее, чем через 5-7 дней. Важно! Нельзя брать мочу из судна.
Советы
СОВЕТ №1
Перед сдачей анализа мочи на бакпосев важно соблюдать правила гигиены. Тщательно промойте половые органы теплой водой без мыла, чтобы избежать загрязнения образца и получения ложных результатов.
СОВЕТ №2
Собирайте мочу в стерильный контейнер, который можно приобрести в аптеке. Убедитесь, что контейнер не поврежден и не содержит посторонних веществ, чтобы избежать искажения результатов анализа.
СОВЕТ №3
Для получения наиболее точных результатов рекомендуется воздержаться от приема антибиотиков и других медикаментов за 48 часов до сдачи анализа, если это возможно. Обязательно проконсультируйтесь с врачом перед прекращением приема любых препаратов.
СОВЕТ №4
После сбора мочи постарайтесь как можно быстрее доставить образец в лабораторию, желательно в течение 1-2 часов. Если это невозможно, храните контейнер в холодильнике, но не дольше 24 часов, чтобы минимизировать риск размножения бактерий.